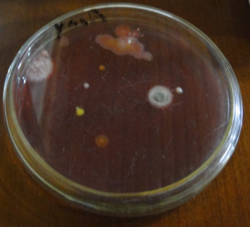

Holidays : May 1, 2026, and May 8, 2026 (Public Holidays in the Czech Republic)
Vacaciones : 1 de mayo de 2026 y 8 de mayo de 2026 (Días festivos de la República Checa)
Gramnegativní bakterie
Z Multimediaexpo.cz
Gramnegativní bakterie mají buněčnou stěnu tvořenou převážně liposacharidy a svrchu překrytou druhou membránou. Následkem toho vycházejí tyto bakterie z Gramova barvení zbarvené růžově, na rozdíl od grampozitivních bakterií, které se jeví jako modrofialové.
Gramnegativní bakterie obsahují v buněčné stěně 17 aminokyselin včetně aromatických aminokyselin. Netvoří spory, množí se příčným dělením. Některé druhy tvoří pouzdra či pochvy. Pohybují se pomocí bičíků nebo plazivě po substrátu.
Mnozí zástupci gramnegativních bakterií jsou patogeny, obecně se považují za nebezpečnější než zástupci skupiny grampozitivních bakterií. Důvod je zpravidla spatřován v některých komponentech jejich buněčné stěny, zejména pak v liposacharidové vrstvě.
Mezi nejdůležitější skupiny gramnegativních bakterií patří proteobakterie (rody Escherichia, Salmonella, Pseudomonas, Moraxella, Helicobacter, Stenotrophomonas, Bdellovibrio, Legionella etc.), sinice, spirochety, Chlorobiaceae a Chloroflexi etc.
Externí odkazy
| Náklady na energie a provoz naší encyklopedie prudce vzrostly. Potřebujeme vaši podporu... Kolik ?? To je na Vás. Náš FIO účet — 2500575897 / 2010 |
|---|
| Informace o článku.
Článek je převzat z Wikipedie, otevřené encyklopedie, do které přispívají dobrovolníci z celého světa. |
